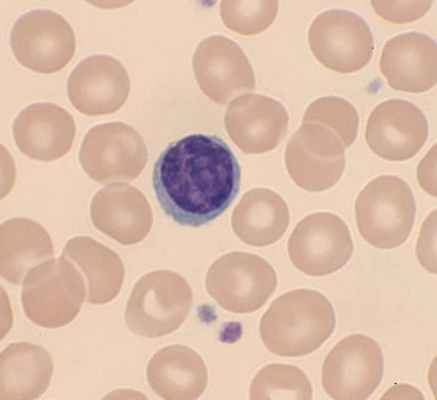

Лимфоциты. Свойства лимфоцитов
Добавил пользователь Алексей Ф. Обновлено: 29.01.2026
Первым исследованием всегда является подсчет лейкоцитарной формулы (см. главу «Гематологические исследования»). Оцениваются как относительные, так и абсолютные значения количества клеток периферической крови.
Определение основных популяций (Т-клетки, В-клетки, натуральные киллеры) и субпопуляций Т-лимфоцитов (Т-хелперы, Т-ЦТЛ). Для первичного исследования иммунного статуса и выявления выраженных нарушений иммунной системы ВОЗ рекомендовано определение CD3, CD4, CD8, CD19, CD16+56, соотношение CD4/CD8. Исследование позволяет определить относительное и абсолютное количество основных популяций лимфоцитов: Т-клетки – CD3, В-клетки – CD19, натуральные киллеры (NK) – CD3- CD16++56+, субпопуляции Т лимфоцитов (Т-хелперы CD3+ CD4+, Т-цитотоксические CD3+ CD8+ и их соотношение).
Метод исследования
Иммунофенотипирование лимфоцитов проводится c использованием моноклональных антител к поверхностным дифференцировочным ангинам на клетках иммунной системы, методом проточной лазерной цитофлуорометрии на проточных цитофлуориметрах.
Выбор зоны анализа лимфоцитов производится по дополнительному маркеру CD45, который представлен на поверхности всех лейкоцитов.
Условия взятия и хранения образцов
Невыполнение этих условий приводит к некорректным результатам.
Интерпретация результатов
Т-лимфоциты (CD3+ клетки). Повышенное количество свидетельствует о гиперактивности иммунитета, наблюдается при острых и хронических лимфолейкозах. Увеличение относительного показателя встречается при некоторых вырусных и бактериальных инфекциях в начале заболевания, обострениях хронических заболеваний.
Снижение абсолютного количества Т-лимфоцитов свидетельствует о недостаточности клеточного иммунитета, а именно о недостаточности клеточно-эффекторного звена иммунитета. Выявляется при воспалениях разнообразной этиологии, злокачественных новообразованиях, после травмы, операций, инфаркта, при курении, приеме цитостатиков. Повышение их числа в динамике заболевания – клинически благоприятный признак.
В-лимфоциты (CD19+ клетки) Снижение наблюдается при физиологических и врожденных гипогаммаглобулинемиях и агаммаглобулинемиях, при новообразованиях иммунной системы, лечении иммунодепрессантами, острой вирусной и хронической бактериальной инфекциях, состоянии после удаления селезенки.
Увеличение отмечается при аутоиммунных заболеваниях, хронических заболеваниях печени, циррозе, муковисцедозе, бронхиальной астме, паразитарных и грибковых инфекциях. Характерно в период реконвалесценции после перенесенных острых и хронических вирусных и бактериальных инфекций. Выраженное увеличение наблюдается при хроническом В-лимфолейкозе.
NK-лимфоциты с фенотипом CD3-CD16++56+ Натуральные киллеры (NK-клетки) – популяция больших гранулярных лимфоцитов. Они способны лизировать клетки-мишени, инфицированные вирусами и другими внутриклеточными антигенами, опухолевые клетки, а также другие клетки аллогенного и ксеногенного происхождения.
Увеличение количества NK-клеток связано с активацией антитрансплантационного иммунитета, в некоторых случаях отмечается при бронхиальной астме, встречается при вирусных заболеваниях, повышается при злокачественных новообразованиях и лейкозах, в периоде реконвалесценции.
Снижение наблюдается при врожденных иммунодефицитах, паразитарных инфекциях, аутоиммунных заболеваниях, облучении, лечении цитостатиками и кортикостероидами, стрессе, дефиците цинка.
Т-лимфоциты хелперы с фенотипом CD3+CD4+ Увеличение абсолютного и относительного количества наблюдается при аутоиммунных заболеваниях, может быть при аллергических реакциях, некоторых инфекционных заболеваниях. Это увеличение свидетельствует о стимуляции иммунной системы на антиген и служит подтверждением гиперреактивных синдромов.
Снижение абсолютного и относительного количества Т-клеток свидетельствует о гипореактивном синдроме с нарушением регуляторного звена иммунитета, является патогномичным признаком для ВИЧ-инфекции; встречается при хронических заболеваниях (бронхитах, пневмониях и т.д.), солидных опухолях.
Т-цитотоксические лимфоциты с фенотипом CD3+ CD8+ Повышение выявляется практически при всех хронических инфекциях, вирусных, бактериальных, протозойных инфекциях. Является характерным для ВИЧ-инфекции. Снижение наблюдается при вирусных гепатитах, герпесе, аутоиммунных заболеваниях.
Соотношение CD4+/CD8+ Исследование соотношения CD4+/CD8+ (CD3, CD4, CD8, CD4/CD8) рекомендовано только для мониторинга ВИЧ-инфекции и контроля эффективности АРВ терапии. Позволяет определить абсолютное и относительное количество Т-лимфоцитов, субпопуляций Т-хелперов, ЦТЛ и их соотношение.
Диапазон значений – 1,2–2,6. Снижение наблюдается при врожденных иммунодефицитах (синдром Ди-Джоржи, Незелофа, Вискотта-Олдрича), при вирусных и бактериальных инфекциях, хронических процессах, воздействии радиации и токсических химических веществ, множественной миеломе, стрессе, снижается с возрастом, при эндокринных заболеваниях, солидных опухолях. Является патогномичным признаком для ВИЧ-инфекции (менее 0,7).
Увеличение значения более 3 – при аутоиммунных заболеваниях, остром Т-лимфобластном лейкозе, тимоме, хроническом Т-лейкозе.
Изменение соотношения может быть связано с количеством хелперов и ЦТЛ у данного пациента. Например, снижение количества CD4+ Т-клеток при острой пневмонии в начале заболевания ведет к снижению индекса, а ЦТЛ при этом могут не измениться.
Для дополнительного исследования и выявления изменений иммунной системы при патологиях требующих оценки наличия острого или хронического воспалительного процесса и степени его активности, рекомендуется включать подсчет количества активированных Т-лимфоцитов с фенотипом CD3+HLA-DR+ и ТNK–клеток с фенотипом CD3+CD16++56+.
Т-активированные лимфоциты с фенотипом CD3+HLA-DR+ Маркер поздней активации, показатель гиперреактивности иммунитета. По экспрессии данного маркера можно судить о выраженности и силе иммунного ответа. Появляется на Т-лимфоцитах после 3-го дня острого заболевания. При благоприятном течении заболевания снижается до нормы. Увеличение экспрессии на Т-лимфоцитах может быть при многих заболеваниях, связанных с хроническим воспалением. Отмечено его повышение у пациентов с гепатитом С, пневмониями, ВИЧ-инфекцией, солидными опухолями, аутоиммунными заболеваниями.
ТNK-лимфоциты с фенотипом CD3+CD16++CD56+ Т-лимфоциты, несущие на своей поверхности маркеры CD16++ CD 56+. Эти клетки имеют свойства как Т-, так и NK-клеток. Исследование рекомендовано как дополнительный маркер при острых и хронических заболеваниях.
Снижение их в периферической крови может наблюдаться при различных органоспецифических заболеваниях и системных аутоиммунных процессах. Увеличение отмечено при воспалительных заболеваниях разной этиологии, опухолевых процессах.
Исследование ранних и поздних маркеров активации Т-лимфоцитов (CD3+CD25+, CD3-CD56+, CD95, CD8+CD38+) дополнительно назначают для оценки изменений ИС при острых и хронических заболеваниях, для диагностики, прогноза, мониторинга течения заболевания и проводимой терапии.
Т-активированные лимфоциты с фенотипом CD3+CD25+, рецeптор к ИЛ2 CD25+ – маркер ранней активации. О функциональном состоянии Т-лимфоцитов (CD3+) свидетельствует количество экспрессирующих рецепторов к ИЛ2 (CD25+). При гиперактивных синдромах количество этих клеток возрастает (острые и хронические лимфолейкозы, тимома, отторжение трансплантата), кроме того, повышение их может свидетельствовать о ранней стадии воспалительного процесса. В периферической крови их можно выявить в первые три дня болезни. Снижение числа этих клеток может наблюдаться при врожденных иммунодефицитах, аутоиммунных процессах, ВИЧ-инфекции, грибковых и бактериальных инфекциях, ионизирующей радиации, старении, отравлении тяжелыми металлами.
Т-цитотоксические лимфоциты с фенотипом CD8+CD38+ Присутствие CD38+ на ЦТЛ лимфоцитах отмечено у пациентов с разными заболеваниями. Информативный показатель при ВИЧ-инфекции, ожоговой болезни. Увеличение числа ЦТЛ с фенотипом CD8+CD38+ наблюдается при хронических воспалительных процессах, онкологических и некоторых эндокринных заболеваниях. При проведении терапии показатель снижается.
Субпопуляция натуральных киллеров с фенотипом CD3- CD56+ Молекула CD56 – адгезивная молекула, широко представленная в нервной ткани. Кроме натуральных киллеров, экспрессируется на многих типах клеток, в том число на Т-лимфоцитах.
Увеличение данного показателя свидетельствуют о расширении активности специфического клона клеток киллеров, которые имеют меньшую цитолитическую активность, чем NK-клетки с фенотипом CD3- CD16+. Количество этой популяции возрастает при гематологических опухолях (ЕК-клеточная или Т-клеточная лимфома, плазмоклеточная миелома, апластическая крупноклеточная лимфома), хронических заболеваниях, некоторых вырусных инфекциях.
Снижение отмечается при первичных иммунодефицитах, вирусных инфекциях, системных хронических заболеваниях, стрессе, лечении цитостатиками и кортикостероидами.
Рецептор CD95+ – один из рецепторов апоптоза. Апоптоз – сложный биологический процесс, необходимый для удаления из организма поврежденных, старых и инфицированных клеток. Рецептор CD95 экспрессируется на всех клетках иммунной системы. Он играет важную роль в контроле функционирования иммунной системы, так как является одним из рецепторов апоптоза. Его экспрессия на клетках определяет готовность клеток к апоптозу.
Снижение доли CD95+-лимфоцитов в крови пациентов свидетельствует о нарушении эффективности последнего этапа выбраковки дефектных и инфицированных собственных клеток, что может привести к рецидиву заболевания, хронизации патологического процесса, развитию аутоиммунных заболеваний и повышению вероятности опухолевой трансформации (к примеру, рака шейки матки при папилломотозной инфекции). Определение экспрессии CD95 имеет прогностическое значение при миело- и лимфопролифератиных заболеваниях.
Повышение интенсивности апоптоза наблюдается при вирусных заболеваниях, септических состояниях, при употреблении наркотических средств.
Активированные лимфоциты CD3+CDHLA-DR+, CD8+CD38+, CD3+CD25+, CD95. Тест отражает функциональное состояние Т-лимфоцитов и рекомендован для контроля за течением заболевания и контроля иммунотерапии при воспалительных заболеваниях разной этиологии.
Иммунная система Часть 4 Лимфоциты
В крови лимфоциты являются частью лейкоцитарной формулы (20-35%), по сути представлены разными популяциями в зависимости от иммунной функции. Образуются в костном мозге из столовой лимфоидной клетки-предшественницы. Общее свойство всех лимфоцитов – участие в иммунной толерантности – способности иммунной системы распознавать и не атаковать собственные ткани. С этой целью клетки, сталкивающиеся со своими антигенами, в процессе созревания, устраняются. Рост, развитие и работа лимфоцитов тесно связаны с особыми молекулами, которые рассмотрим в статьях позже, вводя потихоньку их обозначения.
В-лимфоциты
Развитие В-лимфоцитов происходит в костном мозге, после чего они покидают его и перемещаются в лимфатические узлы.
Зрелый В-лимфоцит выполняет роль антиген-презентирующей клетки и быть источником особых молекулярных веществ для регуляции иммунного ответа. Однако его основная задача вырабатывать антитела.
Для этого необходим контакт с антигеном и несколько дней для превращения В-лимфоцита в плазматическую клетку. В начале образующие антитела представлены иммуноглобулинами класса М IgM. После воздействия особых молекул из Т-лимфoцитов в плазматических клетках синтез антител переключается на классы IgG, IgA или IgE. Помня о встрече с антигеном, В-лимфоциты превращаются в клетки памяти.
При повторной встрече с антигеном, клетки памяти быстро преобразуются в плазматические клетки и сразу секретируют большое количество АТ. А Т-лимфоциты, сохранившие свою память, переключают В-клетки на образование более сильных IgG. Повторная встреча с антигеном нередко протекает незаметно для организма, так быстро и эффективно развивается иммунный ответ.
Т-лимфоциты
Родившись из стволовой клетки костного мозга, предшественники Т-лимфоцитов переходят в тимус, где подвергаются строгому отбору и сортировке. Существует несколько типов Т-лимфоцитов, выполняющих разные функции. Им принадлежит ключевая роль в формировании клеточного или гуморального ответа. Направление иммунитета во многом зависит от особых молекул, которые выделяют антиген-презентирующие клетки.
Тип и подтип Т-лимфоцитов
Способствуют формированию приобретенного иммунитета.
Th1-клетки (Т-хелперы 1 типа)
Активируют фагоцитирующие клетки и клетки-киллеры, выделяют ИФН-гамма, ИЛ-2, ФНО-альфа. Обуславливают приобретенный клеточный иммунный ответ, направленный на внутриклеточные патогены (вирусы), способствуют воспалительной реакции.
Th2-клетки (Т-хелперы 2 типа)
Активно участвуют в выработке антител В-лимфоцитами, выделяют ИЛ-4, ИЛ-5, ИЛ-6, ИЛ-10, ИЛ-13. Обуславливают формирование приобретенного гуморального иммунного ответа, участвуют в противопаразитарном и аллергическом иммунном ответе.
Th17-клетки (Т-хелперы 17 типа)
Производят ИЛ-17, ИЛ-21, ИЛ-22, участвуют в аутоиммунных процессах, в борьбе с внеклеточными бактериями и грибами.
Th0-клетки (Нулевые Т-хелперы)
Наивные клетки, которые должны определиться с выбором. Под действием ИЛ-4, ИЛ-2 превращаются в Th2-клетки; Под действием ИЛ-12, ИФН-гамма в Th1-клетки; Под действием ИЛ-6, ТФР-бета в Th17-клетки.
Т- лимфоциты регуляторные супрессорные
Способствуют завершению иммунного ответа благодаря особым молекулам ТФР-бета, ИЛ-10, ИЛ-13 и другим, подавляющим иммунную реакцию.
Т-лимфоциты цитотоксические и Естественные Т-клетки-киллеры
Необходимы для уничтожения внутриклеточных патогенов, в частности, вирусов. Секретируют ИЛ-4 и ИФН-гамма, регулируют иммунный ответ.
Иммунных клеток гораздо больше, чем мы рассмотрели, они все несут разную функцию, их работа тесно переплетена. Многие иммунные клетки способны вырабатывать особые молекулы, которые регулируют острое воспаление и иммунный ответ.










Выберите город
- Москва
- Санкт-Петербург
- Нижний Новгород
- Армавир
- Астрахань
- Белгород
- Белореченск
- Владимир
- Волгоград
- Воронеж
- Геленджик
- Ейск
- Екатеринбург
- Иваново
- Йошкар-Ола
- Казань
- Калуга
- Кострома
- Краснодар
- Курск
- Лабинск
- Новороссийск
- Орел
- Отрадная
- Пенза
- Пермь
- Ростов-на-Дону
- Рязань
- Самара
- Саратов
- Сочи
- Тверь
- Туапсе
- Тула
- Уфа
- Челябинск
- Ярославль
Годовой абонемент
Годовой абонемент входит в состав первого заказа и дает возможность год Вам и членам Вашей семьи сдавать анализы в два раза дешевле. Результаты всех анализов бессрочно будут храниться в личном кабинете. Подробнее
Лимфоциты - клетки иммунной системы: виды, функции.
Лимфоциты по праву считаются главными клетками иммунитета человека. Такое право они заслужили благодаря многообразию и ценности выполняемых ими задач. Находятся лимфоциты в крови и тканях, обеспечивая клеточный и гуморальный иммунитет. Кроме того, они оказывают воздействие на другие клетки, участвующие в защите организма.
Естественно, что при таком большом количестве функций лимфоциты – это не одна-единственная разновидность, а довольно обширная совокупность видов и субпопуляций клеток, о которых будет подробнее рассказано в других статьях этого раздела. В этом же посте мы поговорим о том, «кто такие» лимфоциты, каково их происхождение и какими они бывают.
Происхождение лимфоцитов:

Лимфоциты в крови, норма которых составляет 20-40% от всех имеющихся в ней лейкоцитов, появляются на свет совсем не в пределах кровеносного русла. Основная их часть образуется в костях, а если точнее, то внутри них, в красном костном мозге. Этот орган известен прежде всего как кроветворная ткань, но в нем образуются не только эритроциты, но и различные виды белых кровяных клеток: моноциты, нейтрофилы, лимфоциты… Предшественниками разных видов лимфоцитов служат стволовые клетки – те самые, которые сейчас так бешено популярны и так активно исследуются. Еще некоторая часть лимфоцитов «рождается» в других органах иммунной системы , таких как тимус ( вилочковая железа ). В этом случае они происходят из лимфоидной ткани . Красный костный мозг
Строение лимфоцитов:
Лимфоциты в крови и тканях человека близко контактируют с другими клетками иммунной системы. Однако базофилы, нейтрофилы, лимфоциты, лаброциты и прочие участники иммунного ополчения, защищающего нас от всевозможных бед, имеют свои индивидуальные особенности. Чтобы отличить их друг от друга, нужно изучить образец крови или ткани под микроскопом.
Лимфоциты обладают небольшими размерами, которые составляют всего около 7-10 мкм в диаметре. Это очень мало. Их размер больше, чем у эритроцитов, однако намного меньше в сравнении с гигантами-макрофагами, которые могут быть в 2-7 раз больше их.
Из «анатомических» особенностей лимфоцитов можно отметить такие их особенности как наличие круглого или овального, крупного ядра и отсутствие зернистости в цитоплазме (содержимом клетки). Это очень важные черты, благодаря которым нормальные лимфоциты отличаются от остальных лейкоцитов. Цитоплазмы в лимфоците может быть мало или много, в первом случае их называют узкоплазменными (фото), во втором – широкоплазменными.
Иногда лимфоциты в тканях отличаются от лимфоцитов в крови: норма это или нет? Да, это нормально. Более того, даже те клетки, которые «живут» в одном месте, имеют между собой некоторые внешние различия, обусловленные тем, что принадлежат к разным видам.
Виды лимфоцитов:
Главные клетки иммунной системы делятся на группы по двум основным критериям.
1. Размер:
2. Функция:
Наиболее часто упоминается разделение лимфоцитов по функции, потому что принадлежность клеток к определенной функциональной группе определяет их вполне конкретное значение в организме.

Т-лимфоциты отвечают за цитотоксический, клеточный иммунитет: они вступают с чужеродными объектами, попавшими в организм, в контакт, и уничтожают их. В-лимфоциты распознают вредоносные частицы и вырабатывают против них особые антитела, обеспечивая гуморальный иммунитет. Наконец, NK-клетки, или натуральные киллеры, отвечают за сохранение нормального клеточного состава организма. Они распознают раковые и другие дефектные клетки и быстро их ликвидируют.
Для полноценной работы иммунной системы содержание лимфоцитов в организме имеет ведущее значение. К сожалению, во многих случаях именно нарушение работы лимфоцитов лежит в основе иммунодефицитных состояний. Чтобы предотвратить появление иммунодефицита или корректировать состояние человека, у которого он уже возник, можно применять препарат Трансфер Фактор. Информационные молекулы этого средства обучают лимфоциты правильно реагировать на проникающих в организм агрессоров.
Лимфоцит, 3D-реконструкция микрофотографии
Курсовой прием Трансфер Фактора позволяет значительно улучшить функции лимфоцитов (особенно натуральных киллеров) и обеспечить крепкий противовирусный, антибактериальный, противоопухолевый иммунитет.
Лимфоциты
Лимфоциты — центральное звено иммунной системы организма. Они отвечают за формирование специфического иммунитета и осуществляют функцию иммунного надзора («цензуры») в организме, обеспечивая защиту от всего чужеродного и сохраняя генетическое постоянство внутренней среды.
Лимфоциты обладают удивительной способностью различать в организме «свое» и «чужое» вследствие наличия в их оболочке специфических участков — рецепторов, активирующихся при контакте с чужеродными белками. Лимфоциты осуществляют синтез защитных антител, лизис чужеродных клеток, обеспечивают реакцию отторжения трансплантата, иммунную память (способность отвечать усиленной реакцией на повторную встречу с чужеродным антигеном), уничтожение собственных мутантных клеток и др.
Каждая из перечисленных функций осуществляется специализированными формами лимфоцитов. Все лимфоциты делятся на три группы: Т-лимфоциты (тимусзависимые), В-лимфоциты (бурсазависимые) и нулевые.

Рис. Характеристика лимфоцитов
Т-лимфоциты
Т-лимфоциты образуются в красном костном мозге из клеток- предшественников, проходят дифференцирование в вилочковой железе и затем расселяются в лимфатических узлах, селезенке или циркулируют в крови, где на их долю приходится 40-70% всех лимфоцитов.
Различают несколько форм Г-лимфоцитов, каждая из которых выполняет определенную функцию: клетки-хелперы (помощники) взаимодействуют с В-лимфоцитами, превращая их в плазматические клетки; клетки-супрессоры (угнетатели) блокируют чрезмерные реакции В-лимфоцитов и поддерживают постоянное соотношение разных форм лимфоцитов; клетки-киллеры (убийцы) непосредственно осуществляют реакции клеточного иммунитета, взаимодействуя с чужеродными клетками и разрушая опухолевые клетки, клетки чужеродных трансплантатов, клетки-мутанты, что сохраняет генетический гомеостаз.
Т-лимфоциты играют ведущую роль в иммунном надзоре. При ослаблении их функций возрастает опасность развития опухолей, аутоиммунных заболеваний (когда собственные ткани организма воспринимаются как чужие), повышается склонность к разным инфекциям.
В-лимфоциты
В-лимфоциты образуются в красном костном мозге, но у млекопитающих проходят дифференцирование в лимфоидной ткани кишечника, червеобразного отростка, нёбных и глоточных миндалин. В крови на их долю приходится 20-30% циркулирующих лимфоцитов. Основная функция В-лимфоцитов — создание гуморального иммунитета путем выработки антител. После встречи с антигеном В-лимфоциты мигрируют в костный мозг, селезенку и лимфатические узлы, где размножаются и трансформируются в плазматические клетки, которые являются продуцентами антител — иммунных у-глобулинов.
В-лимфоциты очень специфичны: каждая группа (клон) реагирует лишь с одним антигеном и отвечает за выработку антител только против него. Среди В-лимфоцитов тоже существует специализация.
Таблица. Сравнительная характеристика Т- и В-лимфоцитов

Нулевые лимфоциты
Нулевые лимфоциты не проходят дифференцирования в органах иммунной системы, но при необходимости способны превратиться в В- или Т-лимфоциты. На их долю приходится 10-20% лимфоцитов крови.
Лимфоциты обеспечивают целостность организма не только путем защиты его от чужеродных агентов. Эти клетки несут макромолекулы с информацией, необходимой для управления генетическим аппаратом других клеток организма. Это имеет важное значение в процессах роста, дифференцировки, регенерации.
γδТ-ЛИМФОЦИТЫ: ОБЩАЯ ХАРАКТЕРИСТИКА, СУБПОПУЛЯЦИОННЫЙ СОСТАВ, БИОЛОГИЧЕСКАЯ РОЛЬ И ФУНКЦИОНАЛЬНЫЕ ОСОБЕННОСТИ
Резюме. γδТ-лимфоциты представляют собой малоизученную гетерогенную популяцию Т-лимфоцитов, доминирующую в слизистых оболочках и сочетающую в себе свойства как клеток врожденного, так и приобретенного иммунитета. Отсутствие процессинга и МНС-рестрикции обуславливает способность γδТ-клеток идентифицировать широкий спектр антигенов, природа которых, как и механизм распознавания, до конца не установлены. Многообразие биологических функций, основными из которых являются цитолиз, иммунорегуляция, презентация антигена и репарация поврежденных тканей, определяют уникальную роль данной популяции при инфекционных, опухолевых и аутоиммунных заболеваниях. В настоящий момент, основные уcилия исследователей направлены на изучение терапевтического потенциала γδТ-лимфоцитов, поиск и продукцию γδТ-клеточных агонистов, а также планирование и оптимизацию терапевтических протоколов, мишенью которых являются γδТ-лимфоциты.
Ключевые слова
Об авторах
иммунологическая группа, Центральная научно-исследовательская лаборатория
220073, ул. Притыцкого, 18, корп. 3, кв. 35. Тел.: (+375-17) 265-33-56. Факс: (+375-17) 265-46-43
иммунологическая группа, Центральная научно-исследовательская лаборатория
Список литературы
1. Adams E., Chien Y-H., Garcia K. Structure of a γδT cell receptor in complex with the nonclassical MHC T22 // Science. – 2005. – Vol. 308. – P. 227 - 231.
2. Beissert S., Schwarz A., Schwarz T. Regulatory T cells // Journal of Investigative Dermatology. – 2006. – Vol. 126. – P. 15-24.
3. Boismenu R., Havran W. Intraepithelial γδT cells exposed by functional genomics // Genome Biology. – 2001. – Vol. 2 –P. 1031-1035.
4. Bonneville M., Scotet E. Human Vγ9Vδ2 T cell: promising new leads for immunotherapy of infections and tumors // Current Opinion in Immunology. – 2006. – Vol. 18. – P. 539-546.
5. Bonneville M. Selection of intraepithelial γδT cells: the holy GrIEL at last? // Nature Immunology. – 2006. – Vol. 7. – P. 791-792.
6. Bonneville M., Fournie J. Sensing cell stress and transformation through Vγ9Vδ2 T-cell mediated recognition of the isoprenoid pathway metabolites // Microbes Infection. – 2005. – Vol. 7. – P. 503-509.
7. Born W., Jin N., Aydintung K., Wands J., French J., Roark C., O’Brien R. γδT lymphocytes – selectable cells within the innate system? // Journal of Clinical Immunology. – 2007. – Vol. 7. – P. 133 - 144.
8. Born W., Reardon R., O’Brien R. The function of γδT cells in innate immunity // Current Opinion in Immunology. – 2006. – Vol. 18. – P. 31-38.
9. Brandes M., Willimann K., Lang A., Nam K., Jin C., Brenner M., Morita C., Moser B. Flexible migration program regulates γδ T cell involvement in humoral immunity // Blood. – 2003. – Vol. 102. – P. 3693-3701.
10. Brandes M., Willimann K., Moser B. Professional antigen-presentation function by human γδT cells // Science. – 2005. – Vol. 309. – P. 264 - 268.
11. Brenner M., McLean J., Dialynas D., Strominger J., Smith J., Owen F., Seidman J., Ip. S., Rosen F., Krangel M. Identification of a putative second T cell receptor // Nature. – 1986. – Vol. 322. – P. 145-149.
12. Carding S., Egan P. γδТ cells: functional plasticity and heterogeneity // Nature Reviews. – 2002. – Vol. 2. – P. 336-345.
13. Cassetti R., Martino A. The plasticity of gamma delta T cells: innate immunity, antigen and new immunotherapy // Cell Mol Immunol. – 2008. – Vol. 5. – P. 161-170.
14. Chien Y-U., Jores R., Crowley M. Recognition by γ/δT cells // Annual Reviews Immunology. – 1996. – Vol. 14. – P. 511-532.
15. Chien Y-U., Konigshofer Y. Antigen recognition by γδT cells // Immunological Reviews. – 2007. – Vol. 15. – P. 46-58.
16. Crowley M., Reich Z., Mavaddat N., Altman J., Chien Y-H. The recognition of the nonclassical major histocompatibility complex (MHC) class I molecule, T10, by the γδT cell, G8 // J. Exp. Med. – 1997. – Vol. 185. – P. 1223-1230.
17. Das H., Groh V., Kuijl C., Sugita M., Morita C., Spies T., Bukowski J. MICA engagement by human Vgamma2Vdelta2 T cells enhances their antigendependent effector function // Immunity. – 2001. – Vol. 15. – P. 83-93.
18. Davis M., Bjorkman P. T cell antigen receptor genes and T cell recognition // Nature. – 1988. – Vol. 334. – P. 395-402.
19. De Rosa S., Andrus J., Perfetto S., Mantovani J., Herzenberg L., Roederer M. Ontogeny of γδ T cells in humans // J. Immunol. – 2004. – Vol. 172. –P. 1637 - 1645.
20. Dieli F., Poccia F., Lipp M., Sireci G., Caccamo N., Di Sano C., Salerno A. Differentiation of effector/memory Vδ2 T cells and migratory routes in lymph nodes or inflammatory sites // J. Exp. Med. – 2003. – Vol. 198. – P. 391-397.
21. Girardi M. Immunosurveillance and immunoregulation by γδT cells // Journal of Investigative Dermatology. – 2006. – Vol. 126. – P. 25-31.
22. Gober H., Kistowska M., Angman L., Jeno P., Mori L., De Libero G. Human T cell receptor γδ cells recognize endogenous mevalonate metabolites in tumor cells // J. Exp. Med. – 2003. – Vol. 197. – P. 163-168.
23. Groh V., Steinle A., Bauer S., Spies T. Recognition of stess-induced MHC molecules by intestinal epithelial γδT cells // Science. – 1998. – Vol. 79. – P. 1737-1740.
24. Hänninen A., Harrison L. γδT cells as mediators of mucosal tolerance: the autoimmune diabetes model // Immunolodical reviews. – 2000. – Vol. 173. – P. 109-119.
25. Hayday A., Tigelaar R. Immunoregulation in the tissues by γδT cells // Nature Reviews. – 2003. – Vol. 3. – P.233-242.
26. Hayday A. γδ cells: a right time and a right place for a conserved third way of protection // Annual Reviews Immunology. – 2000. – Vol. 18. – P. 975 - 1026.
27. Hayday A., Theodoridis E., Ramsburg E., Shires J. Intraepithelial lymphocytes: exploring the third way in immunology // Nature Immunology. – 2001. – Vol. 2 – P. 997-1003.
28. Jameson J., Havran W. Skin γδT cell functions in homeostasis and wound healing // Immunological Reviews. – 2007. – Vol. 15. – P. 114-122.
29. Jomaa H., Feurle J., Luhs K., Kunzmann V., Tony H., Herderich M., Wilhelm M. Vγ9/Vδ2 T cell activation induced by bacterial low molecular mass compounds depends on the 1-deoxy-D-xylulose 5-phosphate pathway of isoprenoid biosynthesis // FEMS Immunol Med Microbiol. – 1999. – Vol. 5. – P. 371-378.
30. Kabelitz D., Marischen L., Oberg H., Holtmeier W., Wesch D. Epithelial defence by γδТ cells // International Archives Allergy Immunology. – 2005. – Vol.137. – P. 73-81.
31. Kabelitz D., Wesch D., He W. Perspectives of gammadelta T cells in tumor immunology // Cancer Research. – 2007. – Vol. 67. – P. 5-8.
32. Kapp J., Kapp L., McKenna K. Gammadelta T cells pla an essential role in several forms of tolerance // Immunology Research. – 2004. – Vol. 9. – P. 93-102.
33. Kronenberg M., Havran W. Frontline T cells: γδT cells and intraepithelial lymphocytes // Immunological Reviews. – 2007. – Vol. 15. – P. 5-7.
34. Kusnierczyk P. Antigen peptide/MHC complex as an initiator of a signal for lymphocyte T activation // Postepy Hiq. Med. Dosw. – 1999. – Vol. 53. – P. 331 - 341.
35. Mincheva-Nilsson L. Pregnancy and γδТ cells: taking on the hard questions // Reproductive Biology and Endocrinology. – 2003. – Vol. 1. – P. 120-131.
36. Morita C., Beckman E., Bukowski J., Tanaka Y., Band H., Bloom B., Golan D., Brenner M. Direct presentation of nonpeptide prenylpyrophosphate antigens to human γδ T cells // Immunity. – 1995. – Vol. 3. – P. 495-507.
37. Morita C., Jin C., Sarikonda G., Wang H. Nonpeptide antigens, presentation mechanisms, and immunological memory of human Vγ2Vδ2 cells: discriminating friend from foe through the recognition of prenyl pyrophosphate antigens // Immunological Reviews. – 2007. – Vol. 215. – P. 59-76.
38. Moser B., Brandes M. γδ T cells: an alternative type of professional APC // Trends in Immunology. – 2006. – Vol. 27. – P. 112-118.
39. Moser B., Eberl M. γδT cells: novel initiators of adaptive immunity // Immunological Reviews. – 2007. – Vol. 215. – P. 89-102.
40. Münz C., Steinman R., Fujii S. Dendritic cell maturation by innate lymphocytes: coordinated stimulation of innate and adaptive immunity // Journal of Experimental Medicine. – 2005. – Vol. 202. – P. 203-207.
41. Nanno M., Shiohara T., Yamamoto H., Kawakami K., Ishikawa H. γδT cells: firefighters or fire boosters in the front lines of inflammatory responses // Immunological Reviews. – 2007. – Vol. 215. – P. 103-113.
42. Odyniec A., Szczepanik M., Mycko M., Stasiolek M., Raine C., Selmaj K. γδT cellsenhance the expression of experimental autoimmune encephalomyelitis by promoting antigen presentation and IL-12 production // The Journal of Immunology. – 2004. – Vol. 173. – P. 682-694.
43. Pennington D., Vermijlen D., Wise E., Clarke S., Tigelaar R., Hayday A. The integration of conventional and unconventional T cells that characterizes cell-mediated responses // Advances in Immunology. – 2005. – Vol. 87. – P.27-59.
44. Poggi A., Catellani S., Fenoglio D., Borsellino G., Battistini L., Zocchi M. Adhesion molecules and kinases involved in gammadelta T cells migratory pathways: implications for viral and autoimmune diseases // Curr. Med. Chem. – 2007. – Vol. 14. – P. 3166-3170.
46. Scotet E., Martinez L., Grant E., Barbaras R., Jeno P., Saulquin X. Tumor recognition following Vγ9Vδ2 T cell receptor interactions with a surface F1 - ATPase-related structure and apolipoprotein A-1 // Immunity. – 2005. – Vol. 22. – P. 71-80.
47. Spada F., Grant E., Peters P., Sugita M., Melian A., Leslie D., Lee H., van Donselaar E., Hanson D., Krensky A., Majdic O., Porcelli S., Morita C., Brenner M. Self-recognition of CD1 by gamma/delta T cells: implications for innate immunity // J. Exp. Med. – 2000. – Vol. 191. – P. 937-948.
48. Tanaka Y., Morita C., Nieves E., Brenner M., Bloom B. Natural and synthetic non-peptide antigens recognized by human γδT cells // Nature. – 1995. – Vol. 375. – P. 155-158.
49. Thedrez A., Sabourin C., Gertner J., Devilder M., Allain-Maillet S., Fournie J., Scotet E., Bonneville M. Self/non-self discrimination by human γδT cells: simple solutions for a complex issue? // Immunological Reviews. – 2007. – Vol. 15. – P. 123 - 135.
51. Thompson K., Rojas-Navea J., Rogers M. Alkylamines cause Vg9Vd2 T cell activation and proliferation by inhibiting the mevalonate pathway // Blood. – 2006. – Vol. 107. – P. 651-654.
54. Wands J., Roark C., Aydintung M., Jin N., Hahn Y.-S., Cook L. Distribution and leukocyte contacts of gdT cells in the lung // J. Leukocyte Biol. – 2005. – Vol. 78. – P. 1086-1096.
55. Wang H., Lee H., Bulowski J., Li H., Mariuzza R., Chen Z., Nam K., Morita C. Conservation of nonprptide antigen recognition by rhesus monkey Vγ9Vδ2 Т cells // J. Immunol. – 2003. – Vol.170. – P. 3696-3706.
56. Zhao H., Nguyen H., Kang J. Interleukin 15 controls the generation of the restricted T cell receptor repertoire of gd intestinal intraepithelial lymphocytes // Nat. Immunol. – 2005. – Vol. 6. – P. 1263-1271.
Читайте также:
